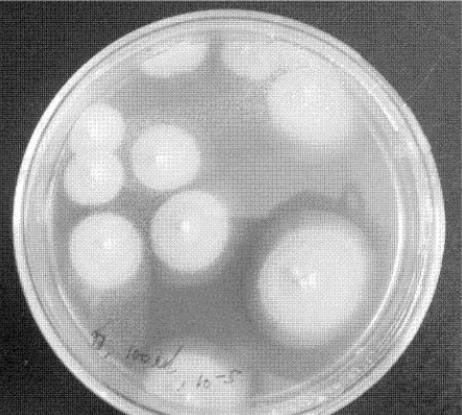

[00018732]一种黄腐酚和黄酮类化合物的萃取分离方法
技术详细介绍
本发明涉及一种黄腐酚和黄酮类化合物的萃取分离方法,步骤如下:用乙醇的溶液浸提酒花及其超临界CO2萃余物,使其中黄酮类化合物尤其是黄腐酚充分溶出;浸提后过滤得滤液,将其减压蒸馏得浓缩液;将浓缩液离心后,取上清液,用0。45μL有机膜过滤,除去部分杂质,用洗脱剂将黄酮类化合物从大孔吸附树脂上洗脱下来,收集流出液,浓缩,冷冻干燥,得黄色粉末。本发明的原料为酒花及其超临界CO2萃余物等,尤其是将酒花制品加工过程中的废料-超临界CO2酒花浸膏萃余物作为主要原料,不但将有主要功效且难以分离的黄腐酚单独提取出来,而且将酒花废料富含的其他黄酮类化合物也一并提取出来,对不能用于啤酒酿造中的酒花也提供了一种开发途径,提高酒花资源利用率和附加值,延长酒花产业链具有重要意义。